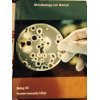
Microbiology Lab Manual Biology 205 1284001202 Book Cover

Microbiology Lab Manual Biology 205
Out of Stock

Evidence-based Practice for Nurses + Access Card
Out of Stock

Cpr Essentials
Out of Stock

Nurse's Drug Handbook
$7.29

Information Systems and Cybersecurity Capstone Project
Out of Stock

Environmental Quality and Health
Out of Stock

Women's Health 6 Edition East Los Angeles College
Out of Stock